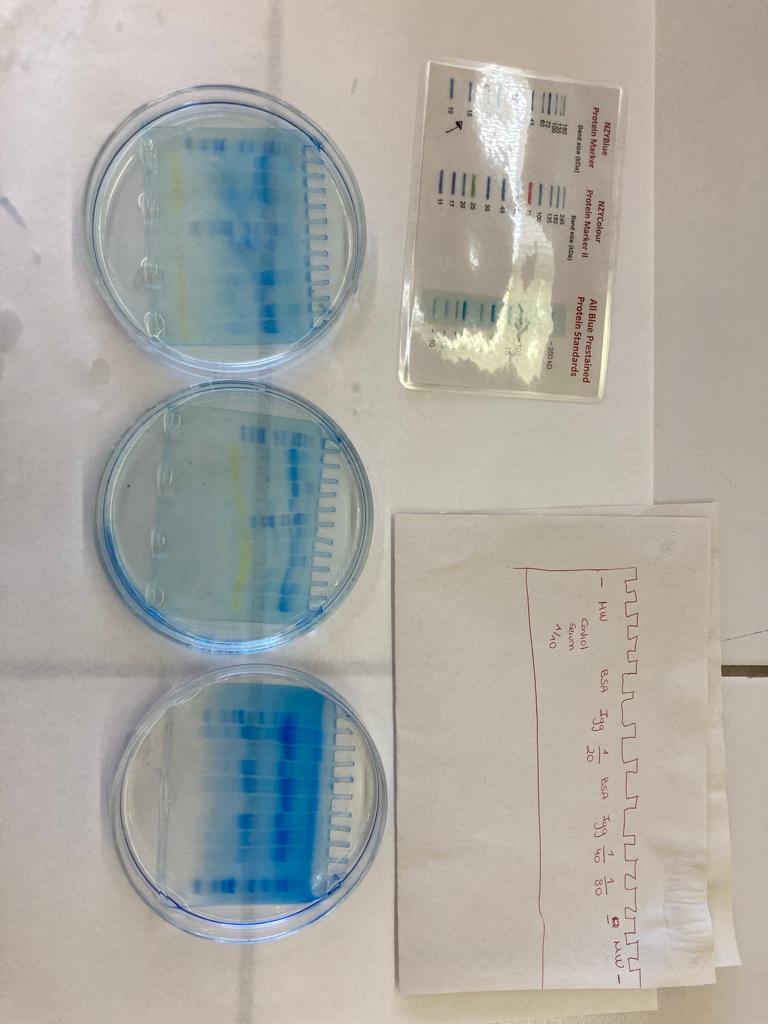

Els alumnes de 1r i 2n de Batxillerat de la matèria de Biologia han realitzat una sortida a la Facultat de Ciència i Tecnologia de la UVic-UCC per dur a terme un taller d’electroforesi (separació i tinció de proteïnes de sèrum boví en gel de poliacrilamida) organitzat pel grup de recerca TR2Lab. Una vegada finalitzat el taller han gaudit d’una visita per altres espais de la facultat i laboratoris de recerca i docència.